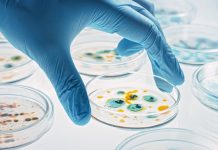

health-021-May-2022 Related News
Harnessing the benefits of hypochlorous acid
Health Europa examines the ever-growing potential of hypochlorous acid, a miracle antibacterial agent that is safe, strong, and sustainable.
On 24 July 1915, a paper...
Why we need urgent action on prostate cancer
As the world struggles to recover from the Covid pandemic and restore critical health services, including cancer services, now is the time to prioritise...
A voice for nurses worldwide
HEQ spoke to Howard Catton, CEO of the International Council of Nurses (ICN) about the unprecedented impact of the COVID-19 pandemic on the nursing...
How the MEP Interest Group on AMR is tackling antimicrobial resistance
Cristina Pricop and Jean-Yves Stenuick outline the key objectives of the MEP Interest Group on AMR whose remit is centred on driving forward the...
Health Europa Quarterly Issue 21
Welcome to Health Europa Quarterly Issue 21, which insightfully explores women’s health, antimicrobial resistance, health policy, infection control, COVID-19, cutting-edge health technology, medical cannabis,...
The importance of patient-centred care for resistance to antibiotics
HEQ spoke to Dr Neda Milevska-Kostova, chair of the International Alliance of Patients’ Organizations (IAPO) and chair a.i. of the AMR Patient Alliance about...
Growing the UK medical cannabis sector through exportation
Jonathan Hodgson, the CEO of Rokshaw Laboratories, and Pierre van Weperen, the CEO of Grow Pharma ltd., outline the vast benefits of exporting medical...
Reviewing the role of air filtration systems in healthcare
The Addenbrooke’s Air Disinfection Study looks set to shape future IPC guidance concerning the implementation of air filtration systems in healthcare settings.
The Addenbrooke’s Air...
FluoretiQ: Fighting AMR with Rapid Diagnostic Systems
FluoretiQ CEO Neciah Dorh shares his vision to improve antimicrobial resistance (AMR) by developing rapid diagnostics that optimise antibiotic use.
The COVID-19 pandemic has made...
Viking Pure Solutions: Safer, sustainable hypochlorous acid cleaning technology
Viking Pure Solutions shares how it is optimising the power of hypochlorous acid for effective cleaning solutions that are non-toxic and safe.
Viking Pure has...
Answering healthcare needs with point-of-care testing
With its advanced point-of-care testing abilities, the LumiraDx platform is enhancing the delivery of care for both patients and healthcare practitioners.
Founded in 2014, LumiraDx...
Working together to enhance patient safety
Professor Eberhard Kochs, vice-president of the European Patient Safety Foundation discusses the reasons behind safety failures in healthcare and the impact of the COVID-19...
The importance of environmental testing
Nova Biologicals outlines the importance of environmental testing to prevent the spread of harmful bacteria and protect public health.
Among the various forms of microbiological...
Inflammatix: Advancing diagnostics for acute infection and sepsis
Inflammatix explores the unmet needs associated with the diagnosis of acute infection and sepsis and how new diagnostic technologies are helping to improve the...
Mitigating medication errors
HEQ spoke to Mike Isles, executive director of the European Alliance for Access to Safe Medicines (EAASM) about the urgent need to tackle medication...
UV-C air disinfection: A powerful weapon for combatting airborne diseases
Troy Cowan, coordinator of the Ultraviolet Working Group at the International Ultraviolet Association outlines the integral role of UV-C air disinfection in fighting the...
‘Antimicrobial resistance is a slow tsunami’
University of Oxford’s Professor Timothy Walsh reflects on the lack of immediacy and accountability in the fight against antimicrobial resistance (AMR) and why bolder...
Supporting innovation in cancer care
With a promising portfolio of innovative projects aimed at advancing the detection and treatment of chronic diseases, EIT Health is improving clinical outcomes for...
Improving rare disease treatment and care
With no cure available for the majority of rare diseases, HEQ spoke to Dr David A. Pearce from the International Rare Diseases Research Consortium...
Digital solutions to enhance the delivery of care
From chatbots combatting vaccine hesitancy to crowd-sourced data informing immunisation services, Health Europa spoke to Moz Siddiqui, head of Strategic Innovation and Partnerships at...